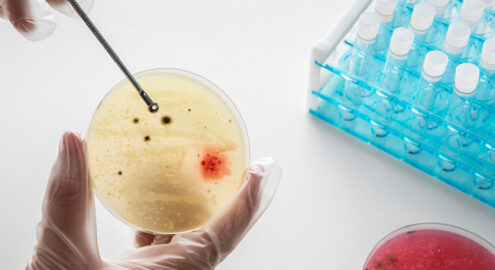

Плановые медицинские проверки помогают сохранять здоровье и продлевать жизнь, а анализ мочи — это один из наиболее простых и информативных способов диагностики. Он помогает выявить различные нарушения работы организма, а также сигнализирует о проблемах обмена веществ и скрытых неполадках в организме.
Без своевременного контроля многие болезни могут долгое время протекать бессимптомно, усложняя дальнейшее лечение. Сдать анализ мочи в Минске можно в медицинском центре «Нордин»! Современные методы лабораторного исследования позволяют получить точные и надежные результаты, а высокий уровень обслуживания делает процесс сдачи анализов быстрым и комфортным для каждого пациента.
Анализ мочи у мужчин помогает выявить
- Нарушения функционирования почек, мочевыводящих путей.
- Воспалительные процессы.
- Заболевания простаты.
- Сахарный диабет и метаболические нарушения.
- Обезвоживание и проблемы с питанием.
Анализ мочи у женщин помогает выявить
- Нарушения почек и мочевыводящих путей.
- Гинекологические воспалительные процессы.
- Беременность и ее осложнения.
- Гормональные и обменные нарушения.
- Сахарный диабет и метаболические проблемы.
- Обезвоживание и проблемы с питанием.
Мы предлагаем следующие виды анализов
- Общий анализ мочи — оценивает физико-химические свойства мочи (цвет, прозрачность, удельный вес, PH мочи), выявляет признаки воспаления, развития инфекции и других патологий.
- Биохимический анализ мочи — определяет уровень белка, глюкозы, креатинина, мочевины и других веществ, что помогает в диагностике заболеваний.
- Микроскопия осадка — исследует клеточный состав мочи (эритроциты, лейкоциты, эпителий), выявляя воспалительные и инфекционные процессы.
- Бактериологический посев мочи — определяет наличие бактерий и их чувствительность к антибиотикам.
- Анализ на соли и кристаллы — помогает выявить риск мочекаменной болезни.
Наши преимущества
- Надежность результатов — современные технологии исключают вероятность ошибок.
- Быстрое выполнение анализов — большинство исследований готовы в течение 1 рабочего дня.
- Комфортные условия сдачи — удобное расположение в центре Минска, гибкий график работы, минимальное время ожидания, комфортные кабинеты для забора биоматериала.
- Комплексный подход — возможность сдать дополнительные анализы для полной диагностики здоровья и проконсультироваться с врачом по результатам исследований.
Для получения точных результатов важно правильно подготовиться:
- За 24 часа до анализа рекомендуется исключить из рациона соленую, жирную, острую пищу, а также продукты, окрашивающие мочу.
- Ограничить прием алкоголя и кофеина, так как они могут повлиять на состав мочи.
- Избегать интенсивных физических нагрузок перед сдачей, так как они могут вызвать появление белка в моче.
- Прием лекарств (антибиотиков, диуретиков) лучше обсудить с врачом, так как они могут исказить результаты.
- Женщинам не рекомендуется сдавать анализ во время менструации, чтобы избежать попадания посторонних примесей.
Этапы взятия образца и его обработки
- Сбор мочи проводится утром, сразу после пробуждения. Используется средняя порция мочи (первые несколько миллилитров спускаются в унитаз, затем наполняется контейнер).
- Используется стерильный контейнер, который можно приобрести в аптеке.
- Биоматериал должен быть доставлен в центр в течение 1-2 часов после сбора, чтобы избежать изменения состава.
В лаборатории образец проходит несколько этапов
- Физико-химическое исследование — определяется цвет, прозрачность, удельный вес, PH мочи.
- Биохимический анализ — выявляются белок, глюкоза, кетоны, билирубин и другие вещества.
- Микроскопия осадка — исследуются клетки, соли, бактерии, кристаллы.
- При необходимости проводится бактериологический посев для выявления инфекций и определения чувствительности к антибиотикам.
Сроки получения результатов
В зависимости от вида анализа и его сложности время готовности может варьироваться от 1 до 7 рабочих дней. Наша лаборатория имеет сертификат качества. Мы гарантируем высокую точность и достоверность результатов.
Приглашаем в медицинский центр «Нордин» для сдачи анализов мочи и других лабораторных исследований! Наши специалисты помогут Вам быстро получить точную информацию о Вашем здоровье. Мы используем современное оборудование, гарантируя достоверность исследований, а приятные условия сделают процесс максимально комфортным.
Счастье быть здоровым!